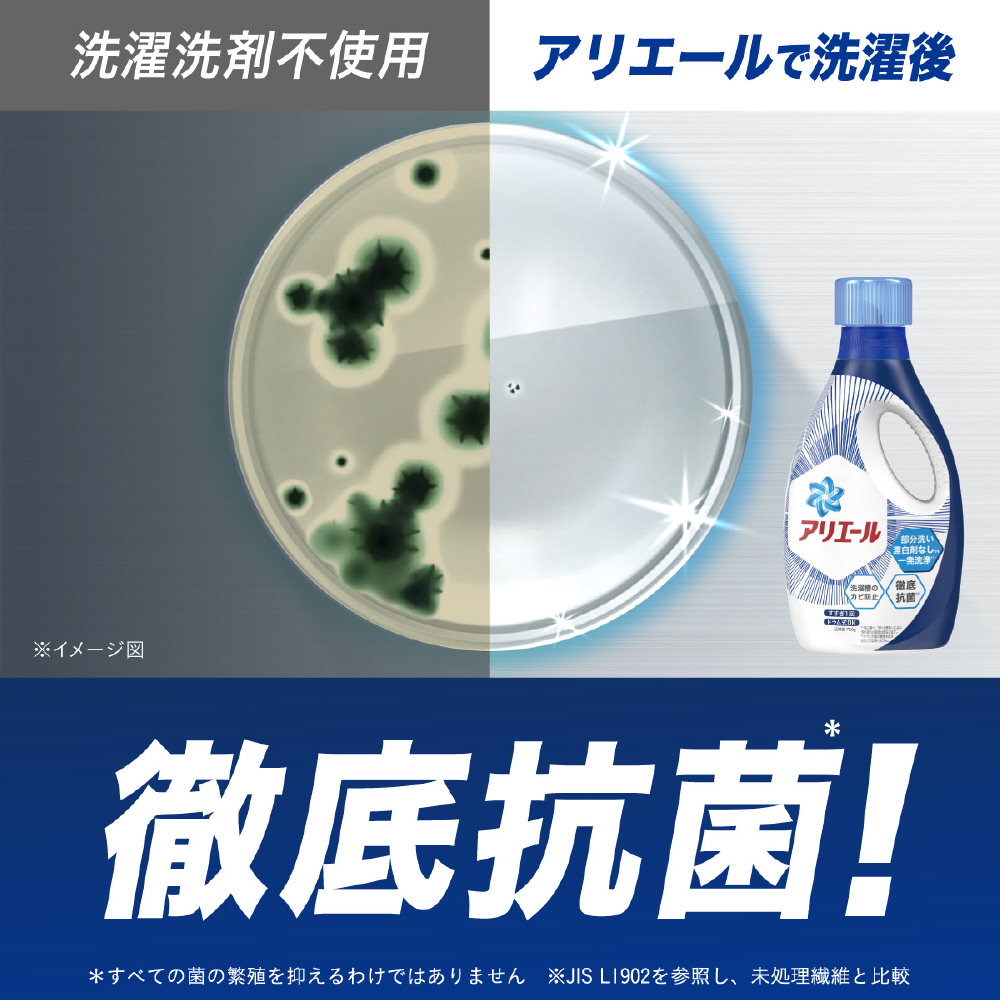

P&G
アリエール バイオサイエンスジェル 洗濯洗剤 詰替 超特大 1000g
部屋干し時のタオルのニオイ癖や生乾き臭まで徹底消臭。
部屋干し時のタオルのニオイ癖や生乾き臭まで徹底消臭。
部屋干し時のタオルのニオイ癖や生乾き臭まで徹底消臭。
たっぷり使える超特大サイズNEW アリエールバイオサイエンス 洗濯洗剤科学x自然洗浄力の限界突破**当社従来品比較持ちやすいハンドル付き 漂白剤なしでも一発洗浄*1徹底抗菌*2洗濯槽のカビ防止 すすぎ1回 ドラム式OK*1 P&G調べ。汚れの度合いにより、汚れ落ちの程度は異なります。*2 すべての菌の増殖を抑えるわけではありません。アリエール, 洗濯洗剤
| 商品名 | アリエール バイオサイエンスジェル 洗濯洗剤 詰替 超特大 1000g |
|---|---|
| 型番 | ARバイオGカエSSL |
| メーカー | P&G |
| 商品番号 | 21275147 |
| JANコード | 4902430521345 |
| メーカー発売日 | 2020年09月中旬発売 |
| ブランド名 | アリエール Ariel |
|---|---|
| 内容量(ml) | 1000ml以上 |
| 本体・詰替え | 詰替え |
| 香り | 香り付き |
| 香り | クリアグリーンの香り |
| 用途 | 綿・麻・合成繊維用 |
| 液性(液体洗剤2) | 弱アルカリ性 |
| 成分 | 界面活性剤(26% ポリオキシエチレンアルキルエーテル、直鎖アルキルベンゼンスルホン酸塩、純せっけん分(脂肪酸塩))、安定化剤、アルカリ剤、分散剤、水軟化剤、蛍光増白剤、酵素 |
| 仕様1 | 内容量:1000g |
| 仕様2 | 洗浄&抗酸化成分配合 |
| 仕様3 | 【使用量目安】 洗濯機(水量)45L:45ml |
レビューがありません